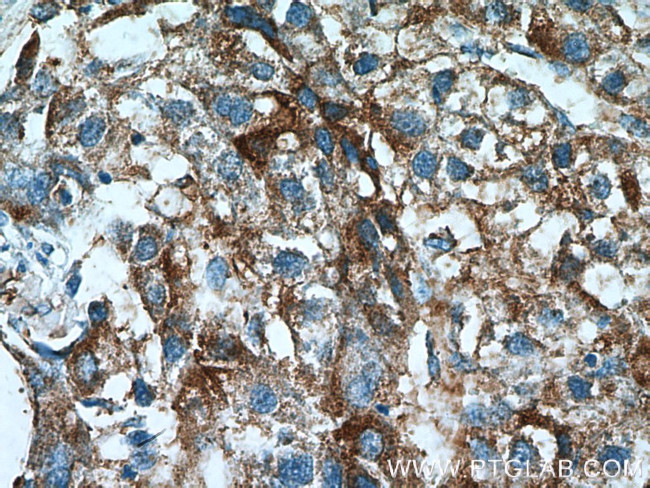
ACSS1 Antibody in Immunohistochemistry (Paraffin) (IHC (P))

Search
Proteintech
ACSS1 Polyclonal Antibody
{{$productOrderCtrl.translations['antibody.pdp.commerceCard.promotion.promotions']}}
{{$productOrderCtrl.translations['antibody.pdp.commerceCard.promotion.viewpromo']}}
{{$productOrderCtrl.translations['antibody.pdp.commerceCard.promotion.promocode']}}: {{promo.promoCode}} {{promo.promoTitle}} {{promo.promoDescription}}. {{$productOrderCtrl.translations['antibody.pdp.commerceCard.promotion.learnmore']}}
产品信息
17138-1-AP
种属反应
已发表种属
宿主/亚型
分类
类型
抗原
偶联物
形式
浓度
规格
纯化类型
保存液
内含物
保存条件
运输条件
产品详细信息
Immunogen sequence: ITGHSYVVY GPLCNGATSV LFESTPVYPN AGRYWETVER LKINQFYGAP TAVRLLLKYG DAWVKKYDRS SLRTLGSVGE PINCEAWEWL HRVVGDSRCT LVDTWWQTET GGICIAPRPS EEGAEILPAM AMRPFFGIVP VLMDEKGSVM EGSNVSGALC ISQAWPGMAR TIYGDHQRFV DAYFKAYPGY YFTGDGAYRT EGGYYQITGR MDDVINISGH RLGTAEIEDA IADHPAVPES AVIGYPHDIK GEAAFAFIVV KDSAGDSDVV VQELKSMVAT KIAKYAVPDE ILVVKRLPKT RSGKVMRRLL RKIITSEAQE LGDTTTLEDP SIIAEILSVY QKCKDKQAAA K (340-689 aa encoded by BC039261)
靶标信息
This gene encodes a mitochondrial acetyl-CoA synthetase enzyme. A similar protein in mice plays an important role in the tricarboxylic acid cycle by catalyzing the conversion of acetate to acetyl CoA. Alternatively spliced transcript variants encoding multiple isoforms have been observed for this gene.
仅用于科研。不用于诊断过程。未经明确授权不得转售。
生物信息学
蛋白别名: AceCS2; Acetate--CoA ligase 2; Acetyl-CoA synthetase 2; Acetyl-coenzyme A synthetase 2-like, mitochondrial; Acyl-CoA synthetase short-chain family member 1; Propionate--CoA ligase; unnamed protein product
基因别名: 1110032O15Rik; Acas2; ACAS2L; ACECS1; AceCS2; AceCS2L; ACSS1; AI788978; KIAA1846
UniProt ID: (Human) Q9NUB1, (Mouse) Q99NB1
Entrez Gene ID: (Human) 84532, (Mouse) 68738, (Rat) 296259